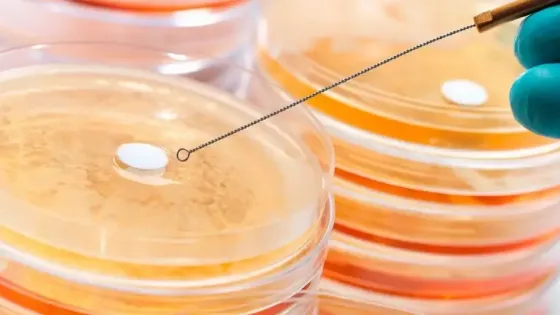
b689b251-746d-4f5e-9478-db939218d728

- Ученые синтезировали новое соединение для борьбы с резистентными патогенами.
- Экспериментальный препарат оказался эффективнее антибиотиков.
- Он обладает большим потенциалом для профилактики лекарственной устойчивости.
- Синтетическое соединение инфузид разрабатывала команда из Великобритании, Франции и Индии.
- Инфузид активен против грамположительных бактерий - золотистого стафилококка и энтерококка.
- Инфузид действовал быстрее антибиотиков и эффективнее уничтожал бактериальные колонии.
- В комбинации с антибиотиком линезолидом эффективность лечения была еще выше.
- Пока инфузид не показал аналогичной эффективности против грамотрицательных бактерий.
- Ученые планируют внести модификации для усиления препарата и расширения его антимикробной активности.
- В случае успеха инфузид может стать альтернативой многим антибиотикам.
Новое соединение эффективно против различных резистентных бактерий
5 июн 2025
Краткий пересказ
от нейросети YandexGPT
Обложка: Изображение из статьи